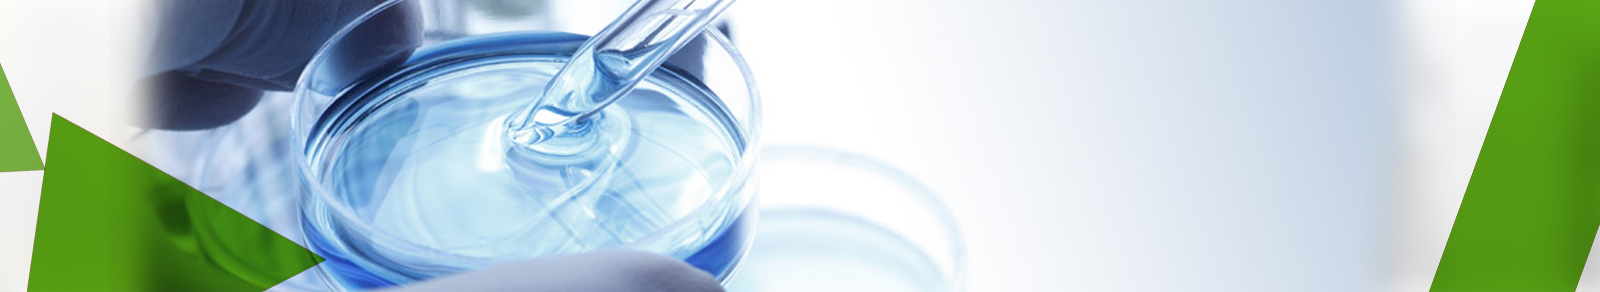
img

The Research and Development wing at Biozone saw its genesis in April 2010, established with an aim ofnurturing its own commercial activities and creating a social impact amongst mankind.Research & Development has always been a focus area at Biozone, the company being driven by a scientific passion. Biozone’s R&D located in Chennai undertakes research programs for multiple Biozone businesses built on a common set of corecompetencies.
Biozone has been dedicated to rigorous and groundbreaking science. The company's emphasis is on strong basic research that has been instrumental to its success and growth. The company also explicitly fosters individual creativity and initiative among its researchers, encouraging scientists to pursue projects of interest in addition to working toward the company's goals.The initial sets ofcore competency areas identifiedare Molecular Biology, HerbalResearch and Plant biotechnology,Microbiology and Mammalian Cellbiology.
R & D atBiozone has always beenapplication oriented keeping inmind the requirements of themarket and the social impact onHumankind in general. The areasof research interest, apart frombeing product oriented includenatural product discovery,molecular diagnostics, bioremediation and insilico approach in drug discovery.

Genomics & Proteomics

The focus of research in the genomics & proteomics lab is on Rapid molecular diagnostics, cancer genomics, molecular marker generation, molecular taxonomy and genetic diversity analysis.
Herbal Research

Natural product discovery with potent anti-cancer, anti-diabetic and anti-microbial properties, understanding the mechanism behind such properties and Biozone Foundation synthesis of nanoparticles with detoxification properties are the major focus of the laboratory.
Animal Cell Culture

Animal tissue culture laboratory of Biozone is a unit of drug discovery and toxicological research using mammalian cell lines. The animal cell culture supports the herbal research division in natural product discovery. The major focus includestoxicology analysis of phytoconstituents andapoptotic pathway analysis of cancer cells treated with medicinal compounds.
Plant Tissue Culture

The Tissue culture division is successfully developing protocols for rapid and mass regeneration of medicinal plants, commercially important plants, ornamental & aromatic plants to conserve the valuable species. The major plants under study are Bacopamonnierei, Withaniasomnifera, Orthosiphonstamineus, Justiciagendarussa and Eupatorium triplinerve. Secondary metabolite production by cell suspension culture is also practiced.
Microbiology

Research on microbial cells at Biozone caters to the necessity of understanding their biology for various applications including Bioremediation, Waste water management, Clinical analysis among others. Microbiology laboratory at Biozone supports the research on development of molecular markers for virulence and antibiotic resistance from clinical and community acquired samples.
Bioinformatics

Bioinformatics research at Biozone facilitates drug research, drug toxicity and pharmaceutical compounding studies. The team also performs research aimed at integrated Bio-IT solutions that include biological databases, chemical databases, data mining. The aim of the Group is to develop novel computational and statistical methods and to engage in collaborative research by working closely together with biologists and clinicians.
Molecular diagnostic kits

The project majorly aimed in developing PCR based rapid diagnostic kits for infectious diseases in general and to identify the resistance patterns in the pathogenic bacteria. Diagnostic kits were developed for antibiotic resistant bacteria like, Klebsiella sp., E.coliand methicillin resistant Staphylococcus aureus. One such ESBL detection kit for gram negative bacteria and MecA detection kit for MRSA were supplied for validation to Stanley Medical College, Chennai.
Inhibitors development for resistance mechanism via efflux pump in Aeromonashydrophila

Among the MDR efflux pumps in anitibiotic resistant pathogens, the AheABC efflux system was taken for this study. The AheABC efflux pump is chromosomally located which confers antibiotic resistance to most of the MDR pathogens. The aim of the study was to screen alternate efflux pump inhibitors from herbal plants. An insilico approach was established by analyzing the receptor of efflux pump and the active phytoconstituents by molecular docking analysis using GOLD (Genetic optimization for ligand docking).
Development of Micropropagation protocols for medicinal & commercial plants

Effective protocols have been developed for rapid and mass regeneration of plants with medicinal and commercial value including Aloe vera, Justiciagendarussa, Rosabourbonia. Plants generated through micropropagation were also subjected for somaclonal variation to ensure the genetic stability.
- Development of molecular markers and alternate drugs for virulent and antibiotic resistant bacteria - Molecular markers are being developed for the rapid and simple diagnosis of pathogenic bacteria. Mutations involved in developing resistance patterns are also being studied.
- Isolation of phytoconstituents with antidiabetic and anticancer properties – Herbal compounds from medicinal plants are being isolated, which have a potent activity against Cancer and Diabetes.
- Establishment of micropropagation methods for selected medicinal plants - Efficient protocols for rapid and mass regeneration of medicinal plants with antidiabetic and anticancer properties are being developed and standardised, to preserve the plant species and their medicinal properties.
- Molecular approach for species identification and genetic diversity using DNA barcodes and biomarkers - The project covers pharmacologically important plants and endophytes, medically important microorganisms and marine organisms. Genetic diversity analysis using recent molecular techniques is also another focus of the project for generating molecular markers. 48 such sequences generated in the laboratory have been submitted to the NCBI GenBank database.
- Development of herbal Anti-biofilm formulations for industrial and medical uses - Herbal formulations with quorum sensing inhibition potentials to target the worldwide problem of biofilm formation are being developed with combined in vitro and insilico approaches.
- Novel efflux pump inhibitors from Indian medicinal plants for MDR pathogens - Hcombat the global medical issue of antimicrobial drug resistance among pathogens, natural compounds are being tested for their ability to inhibit the efflux pumps and re-sensitize the pathogens to existing drugs.
The experience, diversity and dedication of our companystand testimony that we will continue to play a significant role in discovering new innovations helpful to the society.
We solicit collaborative research proposals in the above mentioned fields from academia and industries.
For all collaboration related queries, please write to us at biozone.info@gmail.com